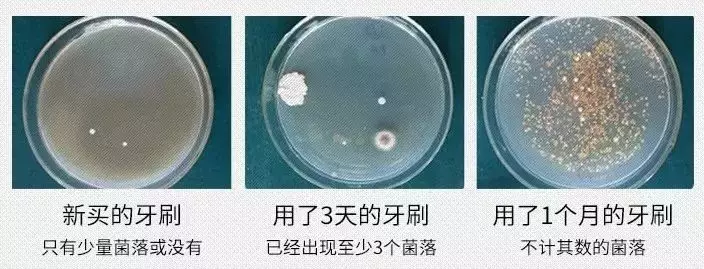
牙刷比马桶水还脏?_细菌

牙刷上的细菌

这是一把使用过很久的牙刷,细菌布满了刷子上
图片尺寸640x481
每天用的牙刷竟然有上百万细菌怎么办
图片尺寸1400x988
别让你的牙刷毒害你了tflash电动牙刷自带消毒健康无忧
图片尺寸800x513
据有关资料统计,一把普通牙刷使用超过4个月,牙刷头上的细菌高达130
图片尺寸673x642
其实这是细菌聚集在牙齿上的放大图; 这是刚刚刷过牙的牙刷被放大后的
图片尺寸485x420
牙刷不消毒细菌赛马桶tflash电动牙刷天天消毒健康无忧
图片尺寸800x578
当牙齿细菌放大了1000倍是不是有些可怕你能看出所以然吗
图片尺寸640x484
手机搜狐网
图片尺寸640x480
牙刷头有多少细菌你知道吗
图片尺寸1080x1080
牙刷和细菌牙科概念
图片尺寸700x525
早起不刷牙就喝水等于喝细菌进肚子今天就来告诉大家答案
图片尺寸660x468
所以存在牙刷上的细菌会爆发性增长,使用一个月后,牙刷就会受到严重
图片尺寸550x309
牙刷比马桶水还脏?_细菌
图片尺寸704x269
男朋友第一次用电动牙刷刷出来的脏东西不忍直视有图有真相
图片尺寸660x681
每天只需60秒牙刷细菌全赶跑钛空好物推荐
图片尺寸1400x888
牙刷比马桶水还脏?_细菌
图片尺寸781x548
牙刷比马桶还脏别急用了它彻底告别细菌
图片尺寸720x597
看完这些,不喜欢刷牙的我也默默拿起了牙刷.
图片尺寸840x602
当你牙齿上的细菌放大一千倍
图片尺寸950x695
看看牙刷上的细菌就知道了!
图片尺寸496x271